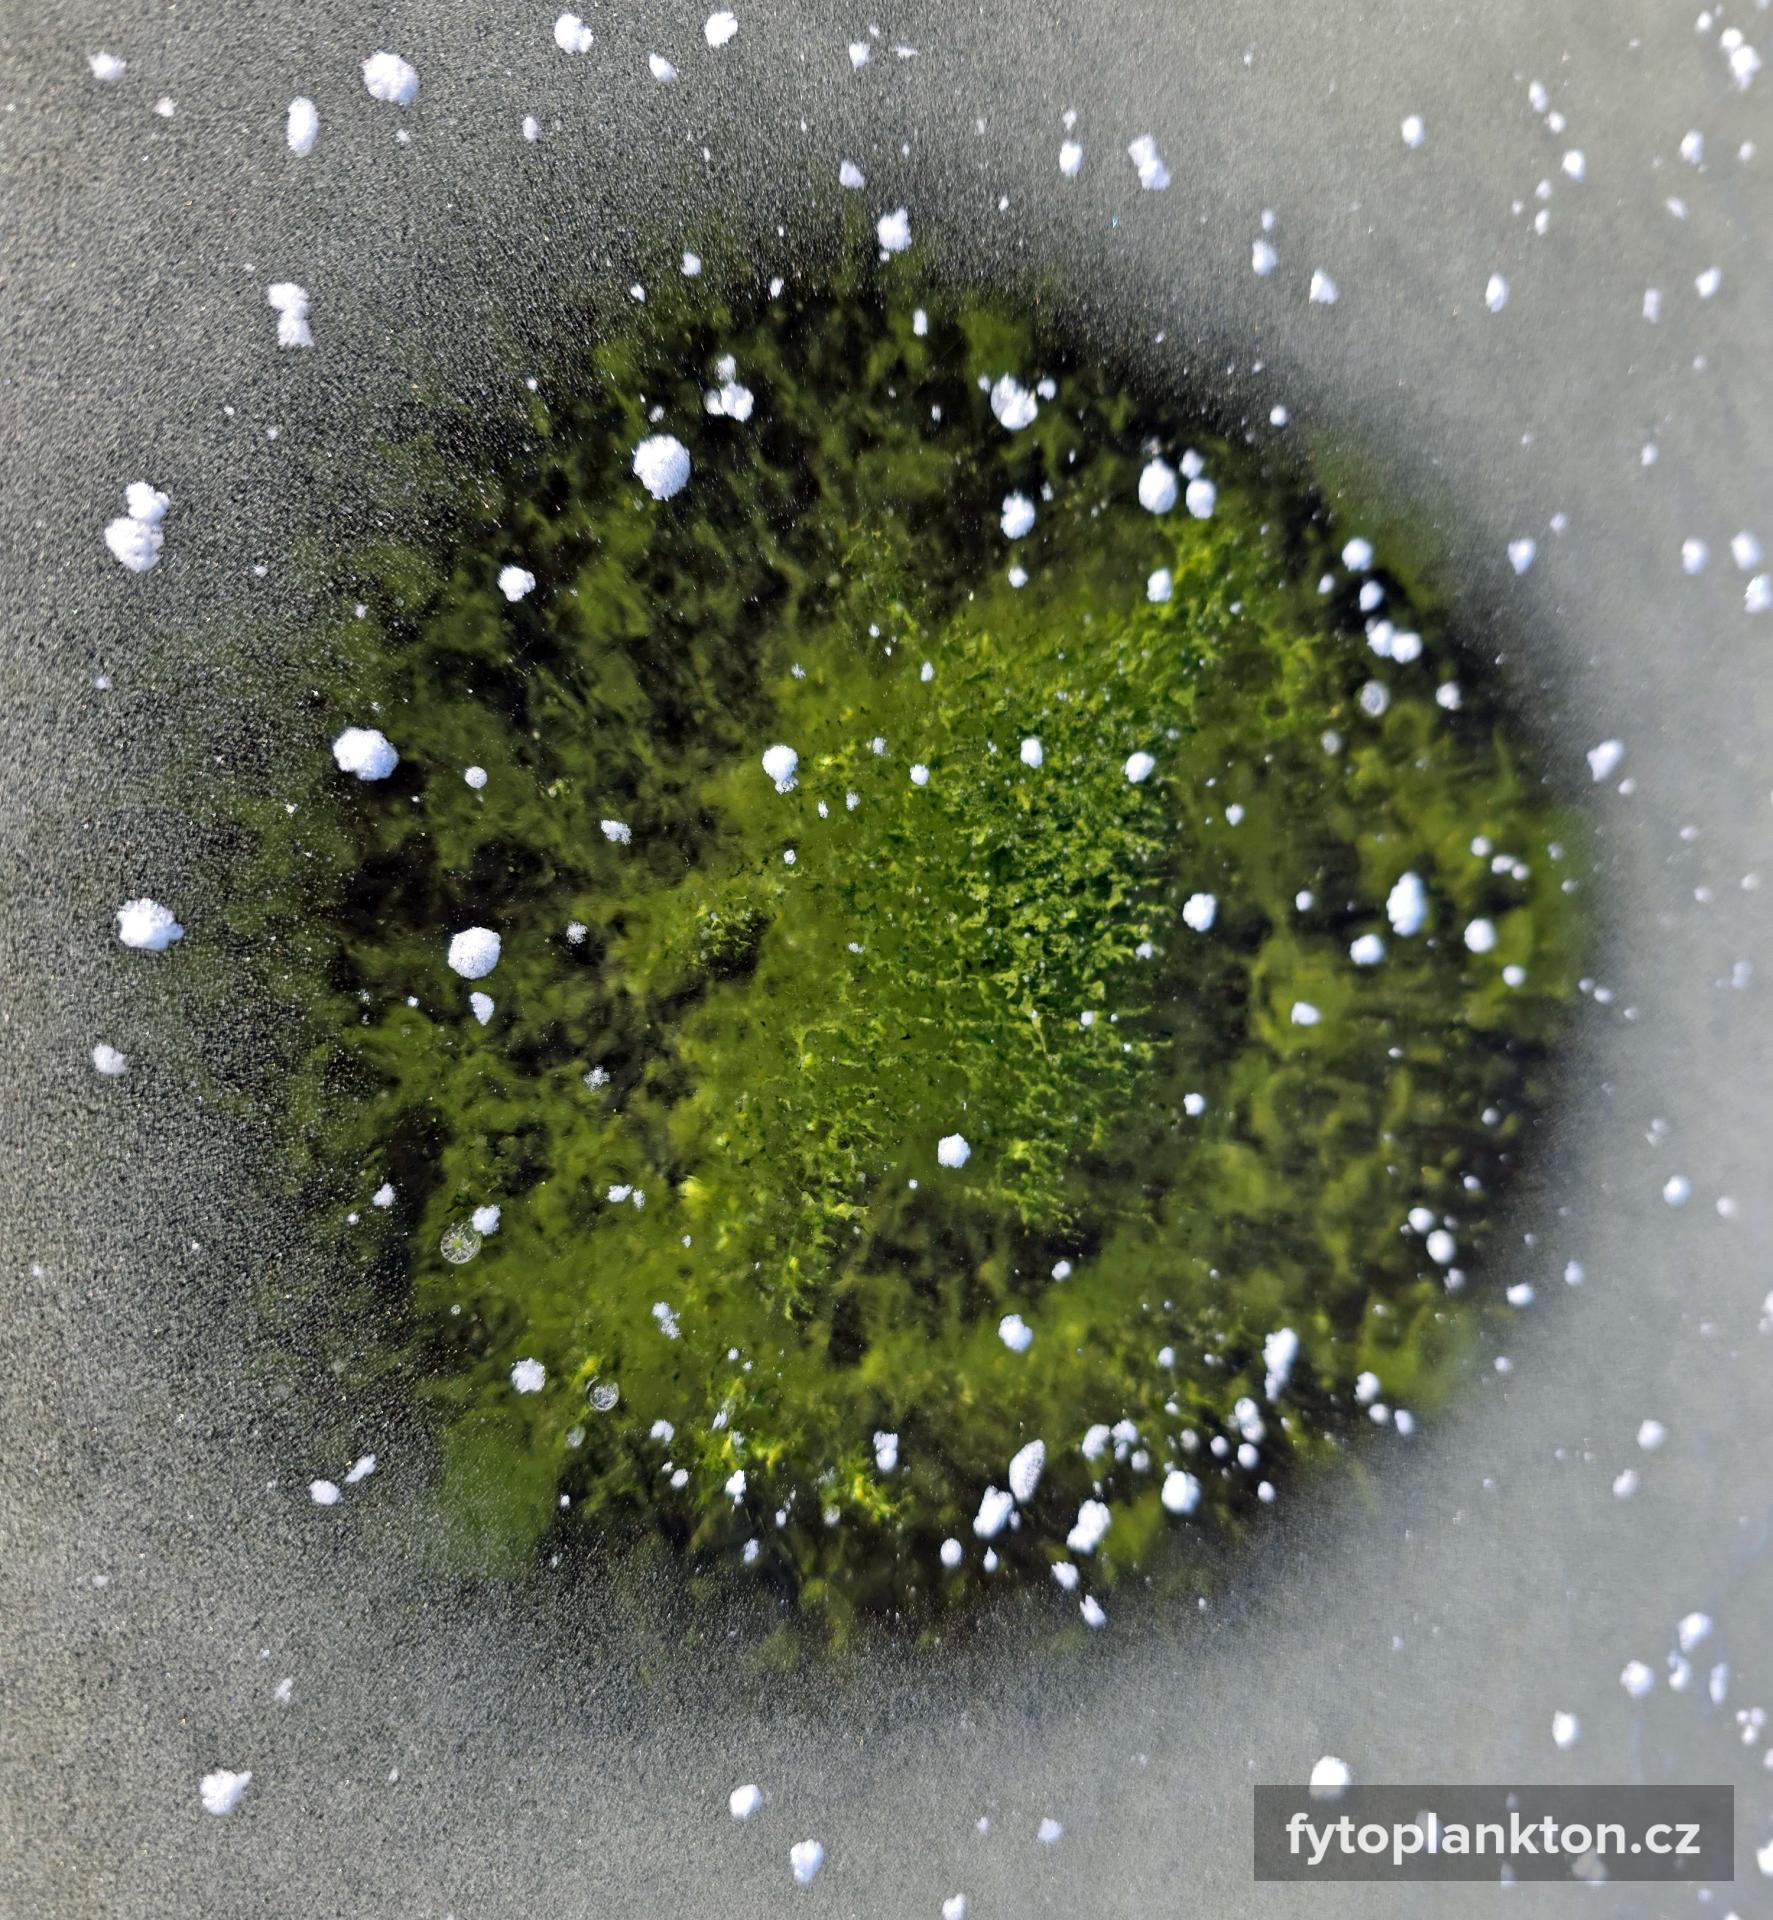

Aktuality
Špinavá voda, čisté odpovědi: Co skutečně stojí za zhoršující se kvalitou vody v Lipně?

Obyvatelé i rekreanti si v posledních letech stále častěji stěžují na zhoršující se kvalitu vody v Lipně. Hlavním viditelným projevem je masivní růst sinic, které zbarvují hladinu do zelena – nově nejen v létě, ale od jara až do pozdního podzimu. Odpovědi na to, co jsou hlavní příčiny znečištění, přináší právě dokončená analytická část Studie příčin znečištění Lipna.
Česká televize - NEDEJ SE!
Lipno septik Šumavy. Odvysíláno 22. 3. 2026

Nádrž Lipno, největší vodní plocha v Česku, je dlouhodobě místem střetu ochrany přírody s rozvojovými plány. Stávající systém kanalizace a čištění odpadních vod už dnes nevyhovuje a odborníci potvrzují, že se zde kvalita vody s každým rokem zhoršuje, což přímo ohrožuje turismus v oblasti. Jak to vidí odborníci? Jaké má Lipno vyhlídky? Dojde k prosazení stavební uzávěry?
Konference Lipensko pro život 2026 již 2.5.2026

Spolek Lipensko pro život z.s. pořádá konferenci určenou všem podporovatelům spolku Lipensko pro život a ostatním milovníkům přírody na Lipensku. Odpolední část konference s odbornými prezentacemi je přístupná široké veřejnosti a účast je bezplatná. Z organizačních důvodů prosíme účastníky o předchozí registraci. Všichni jste srdečně zváni.
Regulační plán v Černé v Pošumaví umožňující postavit přes 200 budov na 19 ha volné krajiny byl soudem zrušen

Regulační plán schválený zastupitelstvem obce Černá v Pošumaví v září 2024 počítal s výstavbou až 2 500 nových rekreačních lůžek v oblasti jihovýchodně od místní části Radslav. Projekt by svou rozsáhlostí překročil velikost nedaleké Horní Plané. Soud vyslyšel námitky občanských spolků, které v žalobě upozornily na závažné nedostatky plánu a regulační plán zrušil.
Rekonstrukce silnice II/141 v úseku Blažejovice – Volary - silniční bezpečnost nebo zbytečná megastavba?

Část silnice II/141, která spojuje Týn nad Vltavou a Volary, čeká v úseku Blažejovice – Volary rekonstrukce. Řešení, které navrhuje Jihočeský kraj je ovšem v mnoha ohledech problematické. Hlavní nedostatek spatřuje spolek Šumava domovem (členský spolek Lipenska pro život) v tom, že naprosto nezohledňuje navýšení intenzity dopravy jako nutný důsledek jeho realizace. Zvýší se silniční bezpečnost nebo se jedná o zbytečnou megastavbu?
Fenomén "zeleného ledu" na Lipně na konci roku 2025
Na konci prosince roku 2025 jsme byli na Lipně svědky velmi neobvyklého ekologického jevu, který lze zjednodušeně a výstižně popsat jako "zelený led". Zelené zbarvení se tentokrát neobjevilo na volné hladině, ale bylo patrné pod ledovou pokrývkou, což vyvolalo řadu otázek i zájem veřejnosti. Podrobnosti se dočtete v odborném článku Petra Znachora, odborníka z Hydrobiologického ústavu Biologického centra AV ČR v.v.i.
Nejvyšší správní soud vrátil Apartmány Pernek k projednání krajským soudem

Na základě žaloby spolku Lipensko pro život musí Krajský soud v Českých Budějovicích znovu projednat, zda měl záměr Apartmány Pernek projít zjišťovacím řízením a zda měly být posouzeny jeho vlivy na životní prostředí. Záměr má vyrůst v lokalitě s místním názvem Jasenka, přímo na břehu Lipna v katastru Horní Plané, a představuje výstavbu cílově až 18 staveb sloužících k rekreaci.
Jak dál se záchranou mlžů na Lipně - co se událo a co se ještě může stát?

Několikaměsíční pozvolný pokles hladiny na Lipně způsobil rozsáhlý zásah do populací velkých mlžů po celém obvodu nádrže — šlo o stovky tisíc jedinců čtyř původních evropských druhů a jednoho druhu invazního. Pokles se nyní na několik týdnů zastavil a díky mírným dešťům se hladina krátkodobě zvýšila z říjnového minima 722,43 m n. m. (stav k 21. 10. 2025) asi o 25 cm. S příchodem ochlazení a úbytkem srážek se však negativní trend opět vrátil a hladina znovu pomalu klesá.
Investor chce u Lipna postavit 25 domů a wellness. 'Jsou tam chránění živočichové,' namítá spolek

Investor chce u Lipenské přehrady mezi Frymburkem a Lipnem nad Vltavou postavit 25 domů s wellness. Po zásahu soudu projekt přejmenoval na bytový komplex Viva Lipno, původně ho prezentoval jako rekreační. Kraj zahájil zjišťovací řízení kvůli posuzování vlivů na životní prostředí. Proti stavbě jsou ekologové a spolky.
Stavební úřad zamítl kontroverzní projekt masivních penzionů na Lojzových Pasekách (Frymburk).

Plánovaná výstavba deseti penzionů v chatové lokalitě u Lipna skončila zamítnutím. Stavební úřad shledal záměr v rozporu s územním plánem a charakterem okolní zástavby.
Rozhodnutí o zamítnutí záměru "Penziony Lojzovy Paseky" představuje významný úspěch v ochraně chráněné krajinné oblasti Šumava před nekoncepční developerskou výstavbou.
Pojďte se s námi podílet na záchraně mlžů na Lipně!

Hladina Lipna je již několik měsíců neobvykle nízká. Tato situace nyní vážně ohrožuje chráněné druhy mlžů žijící ve Vltavě a v nádrži Lipno. Tyto druhy jsou ohroženy zejména rychlým poklesem hladiny vody – nemohou se dostatečně rychle přesunout do hlubších míst a hrozí jim poškození nebo vyschnutí.
Pojďte jim s námi pomoci! Více informací se dozvíte v našem článku!
Co je příčinou nízké hladiny Lipna?

Ačkoli si většina z nás spojuje nádrž Lipno především s rekreací, vodními sporty nebo rybařením, hlavní účel této přehrady je jiný. Účel a pravidla provozu Lipenské přehrady jsou přesně definovány v tzv. manipulačním řádu, který stanovuje, jak má být s vodou v nádrži nakládáno a jaké jsou priority jejího využití.
Příběh zrušeného územního plánu Přední Výtoně

Územní plán je jako mapa budoucnosti města nebo obce — určuje, kde se může stavět, kde zůstane veřejná zeleň, jak budou propojené silnice a veřejná doprava a kde budou služby jako školy nebo obchody. Jak to dopadlo?
Stopka pro obří projekt na Lipensku!

Projekt Rekreační park Kovářov v rámci řízení EIA získal zamítavé stanovisko. A hlavní důvody? Nepřijatelný vliv na krajiný ráz, další vnost znečištění z vlastní lokální ČOV do Lipna, ohrožení řady chráněných druhů a ovlivnění či přímo likvidace stanovišť chráněných druhů.
Celé zamítavé stanovisko si můžete přečíst zde https://portal.cenia.cz/eiasea/download/RUlBX0pIQzkxMl96YXZlcnlTdGFuRE9DXzc1ODIzMzQ2Mzg0ODM1OTUwNTEucGRm/JHC912_zaveryStan.pdf
Mostek v Olšině je kulturní památka

Více informací se dočtete na webu spolku zde https://www.olsina-os.cz/?p=896 a přesnou polohu zmíněného mostku si může zobrazit zde https://mapy.com/s/gajekosuvo
Lipensko pro život se rozrůstá

Osada U Baštýře je již devátým členským spolkem.
Lipensko pro život se rozrostlo o dalšího člena. Je jím spolek Osada U Baštýře, který působí v oblasti Malého Lipna již od roku 2011. Neustálé zhoršování kvality vody v nádrži, developerská výstavba v Mokré či zavedení glampingu do územního plánu přimělo, spolek k širší spolupráci, která vyústila v podání žádosti o členství ve spolku Lipensko pro život z.s. Od. 31. 5. 2025 tak má spolek Lipensko pro život dalších více jak 20 aktivních podporovatelů. Aktivita spolku již není záležitostí několika jednotlivců, ale více jak stovky osob bránících přírodu v oblasti Lipenska.
Soud zamítl další žalobu developera proti spolku Lipensko pro život.

V pořadí již druhou žalobu na ochranu osobnosti, tentokrát ze strany investora See Invest, zamítl dnes 20.5.2025 Krajský soud v Českých Budějovicích.
Předmětem sporu byl facebookový příspěvek, ve kterém spolek v létě 2023 kritizoval záměr "Frymburská pole" v katastru Frymburku. Příspěvek obsahoval devět bodů, které kritizovaly projekt a jeho dopad na životní prostředí. Žalobce tvrdil, že některé z těchto bodů byly nepravdivé a neodůvodněné, a namítal zejména, že žalovaný nepravdivě uvedl, že projekt zahrnuje rozsáhlé kácení a bude mít devastující dopad na krajinný ráz a životní prostředí.
Lipno – jak najít most přes rozbouřené vody

Článek pojednává o vývoji a současné situaci v oblasti Lipna, umělé nádrže v jižních Čechách. Oblast prošla významnými změnami od svého vzniku v 50. letech 20. století, včetně odsunu německy mluvícího obyvatelstva a následné izolace během komunistického režimu. Po pádu železné opony se oblast stala turisticky atraktivní díky své přírodní kráse a divočině. Nicméně, rozvoj turistiky s sebou přinesl nové problémy, jako je zhoršující se kvalita vody a přeměna individuální turistiky v průmyslovou, což ohrožuje samotnou podstatu turistické přitažlivosti oblasti. Článek diskutuje potřebu najít rovnováhu mezi zájmy různých skupin, aby Lipensko zůstalo místem pro život, nikoli jen pro dovolenou.
Starostové na Lipensku podali námitku proti ochraně krajiny.
Jihočeský kraj loni vypracoval 10. změnu Zásad územního rozvoje (ZÚR JčK), která se jako první zaměřuje na ochranu krajiny. Starostové však proti tomuto nástroji, který by jim pomohl chránit krajinu a nastavit udržitelný rozvoj, bojují. Jaký mají důvod?
Lipensko pro život bude žít. Soud vynesl rozsudek.

Na jednání Krajského soudu v Českých Budějovicích dne 8.4.2025 byla zamítnuta žaloba M. Kratochvíla na spolek Lipensko pro život. Žaloba na ochranu osobnosti se týkala facebookového příspěvku spolku zveřejněného počátkem roku 2023, který pojednával o kácení na břehu Lipna.
Kraj posvětil megalomanský projekt v Karlových Dvorech u Horní Plané

Kraj posvětil megalomanský projekt v Karlových Dvorech u Horní Plané, a to navzdory předchozímu zamítnutí a četným námitkám ze strany veřejnosti. Jak je to možné, když byl záměr roce 2022 zamítnut?
Česká televize - NEDEJ SE!
Spirála Lipno. Odvysíláno 16.2.2025
Nádrž Lipno, největší vodní plocha v Česku, je dlouhodobě místem střetu ochrany přírody s rozvojovými plány. Stávající systém kanalizace a čištění odpadních vod už dnes nevyhovuje a odborníci varují, že se zde kvalita vody s každým rokem zhoršuje. Řadu neznámých ohledně stavu vody a příčin jejího znečištění má objasnit odborná studie, která se právě zpracovává.
Developerské chytráctví u Nejvyššího správního soudu narazilo: Resort na Lipně se vydává za bytovou výstavbu, ale ve skutečnosti může být jen rekreačním areálem
Projekt VIVA Lipno v katastru obce Lipno nad Vltavou původně investor předložil jako rekreační areál, poté ho ovšem formálně změnil a označil za bytovou výstavbu, aby se vyhnul nutnosti posouzení jeho vlivů na životní prostředí v tzv. zjišťovacím řízení (EIA) a získal územní rozhodnutí. Nejvyšší správní soud (NSS) nyní rozhodl, že se územní rozhodnutí ruší a projekt musí být ve zjišťovacím řízení EIA posouzen, neboť může ve skutečnosti být jen rekreačním areálem.
Spolky kritizují nedostatečnou redukci projektu Rekreační park Kovářov
Spolky kritizují nedostatečnou redukci projektu Rekreační park Kovářov. Přestože investor snížil počet plánovaných objektů ze 139 na 95, podle místních spolků je redukce nedostatečná a projekt stále představuje významné riziko pro životní prostředí a ohrožení cenné oblasti CHKO Šumava. Předimenzované zastavitelné plochy se přitom dostaly do územního plánu Frymburku již v devadesátých letech minulého století.
Situace na Lipensku pohledem členů spolku a veřejnosti
Milí přátelé Lipenska,
i v adventním čase, který by měl být spíše rozjímavý, bilancující a přátelský, čelí náš spolek stále cílené dehonestační kampani, strategickým žalobám a nepravdivým pomluvám. Obranou je předkládat široké veřejnosti objektivní fakta, což činíme na webu našeho spolku, sociálních sítích a průběžně vydávaným Občasníkem. Nyní připojujeme video, ve kterém se dozvíte další informace.
Tisková zpráva k zahájení stavby v Dolní Vltavici
Společnost SUNNY PORT IN a.s. zahájila výstavbu komunikací a chodníků v Dolní Vltavici u Černé v Pošumaví. Komunikace by měly sloužit areálu "Zóna bydlení a občanské vybavenosti Dolní Vltavice". Výstavba areálu byla podmíněna stavbou ČOV, navýšením kapacity stávající úpravny vody a stavbou vodojemu – realizace ani jedné z těchto uvedených staveb není dosud zahájena.
Srpnový úhyn ryb v malém Lipně v Černé v Pošumaví
V souvislosti se sprnovým úhynem ryb v malém Lipně v Černé v Pošumaví uvádíme dokumenty s rozbory vody, výsledek vyšetření uhynulých ryb a vyjádření Krajské Veterinární správy k úhynu ryb.
Soud dal Hnutí DUHA za pravdu ve sporu o rozšíření silnice na Zadní Zvonkovou
Hnutí DUHA uspělo se žalobou u Krajského soudu v Českých Budějovicích, který zrušil rozhodnutí Ministerstva životního prostředí týkající se výjimky udělené Správou NP Šumava ke škodlivému zásahu do prostředí vzácných a chráněných druhů rostlin a živočichů pro rozšíření úseku silnice z Nové Pece na Zadní Zvonkovou.
Série besed s občany na téma předimenzované výstavby a masové turistiky
11.9.2024 - České Budějovice, Horká Vana, Česká 222/7
Jsou jihočeská krajina a životní prostředí ohroženy? Proč a jak je ochránit?. V jižních Čechách mizí krajina, stále se horší kvalita vody a chystá se výstavba předimenzovaných spaloven. O tom, jak se dá rozvoj dělat, tak, aby byl udržitelný a neničili jsme si kvalitu života budou besedovat řečníci, kteří se těmito tématy dlouho a intenzivně zabývají. Všichni se rozhodli, že je s tím potřeba něco dělat, a proto kandidují na společné kandidátce "Spolu pro lidi a krajinu" do krajského zastupitelstva
Apartmánový komplex VIVA Lipno přišel o důležité razítko
O rekreačním komplexu VIVA Lipno už jsme v Ďáblíku psali vícekrát. Apartmány na břehu Lipenské přehrady, utopené v lese tři kilometry za obcí označil nakonec investor za bytový komplex, aby se vyhnul procesu EIA. A přestože všichni vidí, že o trvalé bydlení nepůjde ani náhodou, zatím tato interpretace hladce prochází úředním kolečkem.
Jedním z razítek, které musí investor získat, je také výjimka ze zákona o ochraně přírody a krajiny, která by povolila zásah do biotopů zvláště chráněných druhů. Původně řízení nemělo vůbec běžet, neboť Městský úřad Český Krumlov ve svém stanovisku napsal, že tam žádné zvláště chráněné druhy nežijí. Teprve po dopisu Cally s výčtem zvláště chráněných druhů z veřejně dostupných databází (NDOP a AVIF), městský úřad svoje stanovisko změnil a investor požádal na krajském úřadě o výjimku.
Spolky Calla a Lipensko pro život se proti vydání výjimky vymezily. Podle našeho názoru není splněná základní podmínka pro její udělení, neboť není doložen veřejný zájem, který by převyšoval veřejný zájem na ochraně zvláště chráněných druhů. Advokát najatý investorem nakonec vymyslel hned několik veřejných zájmů, které by měly výjimku zdůvodnit. Za nejkurióznější považuji veřejný zájem na vysázení původních druhů dřevin. Krajský úřad však nakonec přijal jako relevantní jen jeden z nich a výjimku udělil.
Spolky se proti rozhodnutí krajského úřadu odvolaly k Ministerstvu životního prostředí, které ho kvůli nezákonnosti a nepřezkoumatelnosti zrušilo a vrátilo případ k projednávání zpět na kraj. Spolky se hodlají řízení i nadále aktivně účastnit.
Jiří Řehounek
Vyjádření k rozhodnutí soudu ve věci omluvy spolku za facebookový příspěvek
Dne
21.5.2024 rozhodl Okresní soud v Českém Krumlově o tom, že se má spolek
Lipensko pro život omluvit za facebookový příspěvek a uhradit panu M.
Kratochvílovi nemajetkovou újmu způsobenou tímto příspěvkem. Toto
rozhodnutí zatím nenabylo právní moci. Spolek k tomuto rozhodnutí uvádí,
že spolek byl ochoten o smíru jednat, avšak protistrana jednání
zablokovala navýšením svých požadavků nad rozsah omluvy. Důkazem
vstřícného jednání spolku bylo smazání dotčeného příspěvku. Spolek se
neztotožňuje se závěry soudu ohledně předmětného příspěvku ani o jeho
dosahu, který mu byl tímto rozhodnutím soudu přisouzen. Spolek se
zároveň nemůže ztotožnit se závěrem soudu, že osoba p. Kratochvíla není
v souvislosti s ochranou přírody a životního prostředí na Lipensku
kontroverzní. Spolek trvá na tom, že v rámci řízení u soudu nebyla
prokázána žádná újma a tedy přiznaná výše nemajetkové újmy je zcela
neopodstatněná a pro spolek naprosto likvidační. Spolek se tedy rozhodl
v této věci odvolat. I přes výše uvedené se spolek bude i nadále snažit
bojovat za to nejdůležitější, a to ochranu lipenské přírody.
Lipensko pro život, z.s.
Nové vydání č. 5 našeho občasníku

Pokračování přehledu projektů na Lipensku, proč je důležité sledovat územní plán obce, žirafy převlečené za slony u Lipna nad Vltavou a předražený obchvat u Nové Pece - to a mnohem více najdete v novém vydání č. 5 našeho občasníku.
Česká televize - NEDEJ SE!
Horký brambor v Nové Peci. Odvysíláno 17.3.2024
Dotčený sporný úsek zvaný obchat Nové Chalupy také sledujeme. Pozitivní stanovisko EIA (posuzování vlivů na životní prostředí) je staré 13 let. Bez dalších průzkumů byla jeho platnost v roce prodloužena až do roku 2028. V plánované trase bylo ale zjištěno několik druhů silně ohrožených a zvláště chráněných druhů motýlů, rostlin a obratlovců. Jsme zvědavi na další informace v pořadu.
Žirafy, sloni a apartmány na Lipně
V lednovém vydání časopisu Ďáblík (https://www.calla.cz/data/dablik/cisla/dablik241.pdf) organizace Calla (https://www.calla.cz/) vyšel článek, který zajímavým způsobem popisuje rozdíl v posuzování stavebních záměrů a jejich vlivu na životní prostředí.
Když je něčeho moc, tak je toho příliš. V novém Občasníku přinášíme přehlednou mapu záměrů na Lipensku.
Vydali jsme nový Občasník č. 4, ve kterém najdete kompletní přehled developerských záměrů, o kterých máme povědomí. Více se o jeho obsahu dozvíte v newsletteru z 5.12.2023 https://www.lipenskoprozivot.cz/newsletter/
Nový Občasník si můžete přečíst zde: https://www.lipenskoprozivot.cz/obcasnik/
Tištěnou verzi si můžete zdarma vyzvednout na kterékoliv pobočce:
- Jihočeské vědecké knihovny v Českých Budějovicích,
- Městské knihovny v Českém Krumlově, nebo
- v kavárně Fér Café, Česká 153/38, České Budějovice.
Jak ve věci ochrany Lipenska pokročil Kraj se půjdeme zeptat na zasedání zastupitelstva Jihočeského kraje 14.12.2023. Přijďte nás podpořit nebo sledujte zasedání online. Naše vystoupení budou na konci zasedání.
Projednávání petice na zastupitelstvu v Lipně nad Vltavou
Dne 7.9.2023 jsme se zúčastnili jednání zastupitelstva v Lipně nad Vltavou, které projednalo petici "Zastavte budování dalších sjezdových tratí na Lipensku".
Video ze zasedání najdete zde: Odkaz
Petici k počátku října podepsalo celkem 2020 lidí, z toho 105 občanů trvale žijících v Lipně nad Vltavou (tj asi 16% obyvatel této obce). Petice je stále dostupná elektronicky zde na webu: Odkaz
Jak jsme i očekávali, zastupitelstvo nám nevyšlo vstříc ani v jednom z požadavků.
Přečtěte si článek, který jsme zaslali k otištění do zpravodaje obce. Obsahuje i odkazy na studie a jiné zdroje informací.
31.10.2023 byla v Českých Budějovicích ukončena putovní výstava Krajina LIPNA!
Vernisáž výstavy Krajina LIPNA proběhla 2. května v Městské knihovně v Českém Krumlově.
Video z akce a více informací najdete v reportáži na stránkách Českokrumlovského deníku.
Více informací o výstavě na: Studie Krajina LIPNA






Česká televize - NEDEJ SE!
Vypůjčená krajina. Odvysíláno 19.2.2023
SKVĚLÁ REPORTÁŽ O DĚNÍ NA LIPNĚ NA TÉMA ROZŠIŘOVÁNÍ SKIAREÁLU
Skutečně je rozumné obětovat 20 ha zdravého lesa kvůli dalším 7 novým sjezdovkám, když už jich je v oblasti asi 13? Dává to vůbec ještě ekonomicky smysl?
- Jak to, že je starostům dotčených obcí Loučovic a Lipna nad Vltavou jedno, že někteří jejich občané a majitelé nemovitostí přijdou o své zdroje vody?
- Mnozí občané s dalším rozšířováním nesouhlasí. Ke konci února jich podepsalo petici proti výstavbě dalších sjezdovek a rozšiřování Skiareálu Lipno již 1705 a další podpisy přibývají.
Odkaz na petici zde: Sjezdovky
Záznam z besedy s odborníky, investory a místními obyvateli na téma nové sjezdové tratě a lanové dráhy v Loučovicích, která proběhla v sobotu 25.2.2023.
Nás spolek společně s obyvateli Loučovic a Lipna nad Vltavou zorganizoval již druhou besedu na téma rozšiřování Skiareálu o dalších 7 sjezdových tratí a 3 lanovek v blízkosti jejich obcí.
O problémech spojených s tímto rizikovým podnikáním hovořil pan profesor RNDr. Jaroslav Vrba CSc. z Jihočeské univerzity v Českých Budějovicích.


Studentky architektury vytvořily svou vizi rozvoje a ochrany krajiny Lipenska
Přečtěte si článek: Českokrumlovský deník
Máme ohromnou radost, že nás v našem úsilí podporují také mladí lidé, kteří si plně uvědomují závažnost současného nakládání s krajinou v okolí Lipna.
A pozor, článkem v médiích to teprve začíná!
Můžete se těšit na plánovanou výstavu jejich práce v Českých Budějovicích, Českém Krumlově a v několika lipenských obcích.
Více na našich stránkách v sekci Studie Krajina Lipna
Chystá se další megalomanské rozšiřování sjezdových tratí!
POMOZTE NÁM TO ZASTAVIT! Nová petice
Celkově se jedná minimálně o sedm nových sjezdových tratí, kterým má padnout za oběť více než 20 ha zdravého lesa!
Právě probíhá zahájení územního řízení týkajícího se výstavby pěti nových sjezdových tratí v celkové délce 6,5 km a dvou lanových drah o délce 1,5 km! Ale to není vše! Další projekt bude následovat, neboť v červenci prošel procesem posuzování dopadů na životní prostředí další projekt, SAL Loučovice firmy Lipno Servis, který má přinést další dvě sjezdovky a způsobit další odlesnění v rozsahu 4 ha nad nádražím v Lipně nad Vltavou!
Všechny sjezdovky mají být umístěny v katastrálním území Lipna nad Vltavou a Loučovic u Dvorečné.
Developerský záměr Karlovy Dvory dostal od Krajského úřadu
v říjnu 2022 stopku!
Chceme Vás seznámit se zdůvodněním nesouhlasného stanoviska. Zdůvodnění má 32 stran, je skvěle zpracované a dělá oponentnímu posuzovateli a pracovníkům Krajského úřadu v Českých Budějovicích čest.
Jaké byly ty nejzásadnější výhrady, které jsou ve zdůvodnění uvedeny?
- Unese to krajina a životní prostředí? ...aneb nevyhodnocené kumulativní vlivy
Chybělo vyhodnocení stavu životního prostředí z hlediska jeho únosného zatížení - tedy jestli tento projekt krajina ještě unese. Každý záměr, který vstupuje do území jako "poslední", musí zohlednit existující míru již existujících negativních vlivů v daném území, přizpůsobit jim své technické řešení a dále navrhnout opatření pro omezení vlivů nového projektu, což se nestalo.
- Soulad s územním plánem
Soulad s územním plánem pro schválení záměru nestačí! Kraj tuto argumentaci odmítl a uvedl, že "soulad s územně plánovací dokumentací je v případě posuzování vlivů na životní prostředí informativní a nijak záměr nepředurčující".
- Nový sídelní útvar v CHKO
Záměr by krajinu prakticky přeměnil na nový sídelní útvar. To je ale v rozporu s Plánem péče Chráněné krajinné oblasti Šumava (hurá! Jen jestli o tom CHKO Šumava ví, když pan ing. Huszár i k tomuto projektu opět vydal pozitivní stanovisko).
- Voda
I malé zvýšení znečištění způsobené dalším vnosem odpadních vod může znamenat překročení únosné míry zatížení již tak značně zatížené vody v přehradě a mít tak negativní vliv na životní prostředí i veřejné zdraví. Kumulativní vliv nebyl v tomto ohledu vyhodnocen.
Přitom požadavek na vyhodnocení celkového dopadu stávající rekreační výstavby na nádrž Lipno před pokračováním v další výstavbě byl vznesen dokonce i Povodím Vltavy!
- Rozsáhlý zábor ZPF, urbanizace a dopad na krajinu
Jedná se o příliš rozsáhlý zábor kvalitní půdy Zemědělského půdního fondu. Tento naddimenzovaný záměr by měl významný dopad nadlokálního charakteru, který by oproti současnému stavu výrazně změnil přírodní a krajinné podmínky dotčeného území:
"Celkově lze konstatovat, že z pohledu zpracovatele posudku byla podhodnocena velikost a významnost vlivů na krajinu a krajinný ráz s ohledem na výraznou urbanizaci části levého břehu Lipna východně od Jenišova k Hůrce na území CHKO Šumava, vliv na půdu s ohledem na zábor půd v I. třídě ochrany a vliv na povrchové vody s ohledem na možné kumulace jednotlivých plánovaných záměrů a vznosu nového znečištění do území. Zároveň absence zhodnocení únosnosti stávajícího stavu životního prostředí v místě realizace záměru dle názoru zpracovatele posudku neumožňuje korektní vyhodnocení vlivů záměru."
Spolek chatařů a majitelů loděnic Radslavská zátoka vystoupil na zasedání Krajského úřadu Jihočeského kraje
Dne 15.09.2022 jsme se zúčastnili zasedání Krajského úřadu Jihočeského kraje, abychom připomněli zastupitelům a Krajskému úřadu, že dluží našim občanům již 5 měsíců odpověď!
Při té příležitosti je naše kolegyně Dana Špatenková ze spolku Spolek chatařů a majitelů loděnic Radslavská zátoka seznámila s tím, jak probíhalo léto 2022 na Malém Lipně a nasdílela videozáznam kvality vody.
ekolist.cz, 28.06.2022
Petr Svoboda: Zákon o ochraně přírody a krajiny po 30 letech: zmlácený mrzák v ringu se stavební lobby.
"osud českého zákona o ochraně přírody a krajiny připomíná život knížete Jaromíra. Uprostřed svárů o knížecí trůn na přelomu prvního a druhého tisíciletí ho jeho soupeři nejprve oslepili, poté vykleštili, a nakonec ho najatý vrah schovaný pod stolicí suchého záchodu probodl zespodu kopím."
Dnešní legislativa ani zodpovědné orgány nezajišťují dostatečnou ochranu ani náhodou. Řízení jsou časti výsměchem přírodě i lidem. Ochrana jen naoko a pro někoho jde všechno.
Jak dlouho si necháme přírodu vykrádat?
Besedy s občany v Horní Plané a ve Frymburku
V dubnu a v květnu roku 2022 se uskutečnily besedy s občany v Horní Plané a ve Frymburku.
Bylo plno! Skvělá atmosféra!
Lidé se dozvěděli:
- proč je voda v Lipně v tak špatném stavu
- proč je jasné, že to přímo souvisí s výstavbou nových rekreačních areálů,
- proč je tak důležité chránit i levý břeh, nejen ten pravý
- jak ohromný je rozsah nově plánované výstavby
- jak pokračuje jednání s Krajským úřadem Jihočeského kraje
Pořad NEDEJ SE!
Jihočeské moře betonu. Odvysíláno 6.3.2022
Rekreace je s vodní nádrží Lipno nerozlučně spjata. Díky turismu se region transformoval a z něho i prosperoval. Pokud však bude dále nekontrolovaně bujet, je pravděpodobné, že přispěje k rozvratu ekosystému a nenávratné proměně celé lipenské vodní nádrže.



